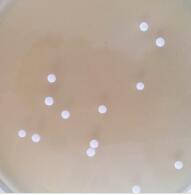
活性菌剂

济南瑞丰生物工程有限公司
联系人:陆奉勇
电 话:0531-87483989
手 机:13905416779
邮 箱:13905416779@163.com
邮 编:250308
网址:www.jnrfsw.com
地 址:山东省济南市长清区张夏工业园区
在市场上有很多人用白酒发酵菌剂做酱香型酒,但是质量参差不齐,质量差的酱香型就生产流程简单,生长周期短,价格也比较便宜,不属于正宗的酱香型白酒,那么我们怎样才能鉴别酱香型白酒的好坏呢?
一、我们可以在盘子里面倒入少量的酱香型酒,量不必多,盖住盘底就好,然后把酱香酒燃烧后制作成裸体酒,再把酱香型酒倒入高脚杯里,看一下是否呈现透明清澈的。
二、酱香型酒中的乙醇燃烧完之后,剩下的东西就是粮食的发酵物,它一定是不透明的、浑浊的,喝到嘴里是酸酸的,后味是类似酒糟的甜香味,这是鉴别酱香型白酒最简单的方法。
提醒大家白酒发酵菌剂在酿造白酒的过程中对水质的要求是非常的严格的,水的质量直接影响着酒品的质量,那么在酿造白酒的过程中对水质具体有哪些要求呢?接下来我们大家一起来了解下吧。
1.我们在酿酒时水源应该选择符合工业用水的条件水质必须优良、清洁、水温低,这样才能酿造高品质的白酒。
2.酿造白酒的水质在口味上要求味净微甘、具有清爽气味,不能有异杂味,这样的水质才是符合标准的。
3.水质在外观上在外观上要求无色透明,无悬浮物,无沉淀,凡是呈现微黄、混浊、悬浮的小颗粒的水,必须经过处理才能使用。
4.白酒酿造时在碱度方面用水的标准应该为PH6-8,因为水中适当的碱度可降低酒醅的酸度。
